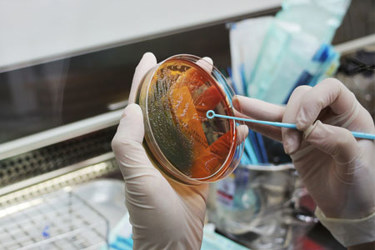

Monitoring Microbial Contamination Of Mammalian Cell Cultures With The Milliflex® Rapid System 2.0
In the realm of biopharmaceutical manufacturing, the Milliflex® Rapid System 2.0 emerges as a crucial tool for monitoring microbial contamination in mammalian cell cultures. This application note delves into the system's innovative use of membrane filtration and ATP bioluminescence to identify viable microbial contaminants. However, the challenge of false positives arising from ATP produced by mammalian cells necessitated the development of a specialized cell lysis buffer, which has recently undergone reformulation to comply with updated European Chemicals Agency (ECHA) guidelines. The revised lysis buffer effectively lyses mammalian cells, thereby eliminating their ATP interference during sample preparation. This enhancement significantly improves the specificity of microbial detection, which is particularly vital for short-life products such as CAR-T cell therapies.
A methodology for assessing microbial contamination details experimental conditions and the use of various microorganisms, including Gram-positive and Gram-negative bacteria, yeast, and molds. Results indicate that the new lysis protocol not only reduces false positives but also maintains microbial recovery rates between 72% and 106%. This advancement underscores the importance of precise microbial monitoring in ensuring patient safety and product integrity, ultimately reinforcing the reliability of the Milliflex® Rapid System 2.0 in biomanufacturing processes.
Access the full application note to learn more.
Get unlimited access to:
Enter your credentials below to log in. Not yet a member of Cell & Gene? Subscribe today.